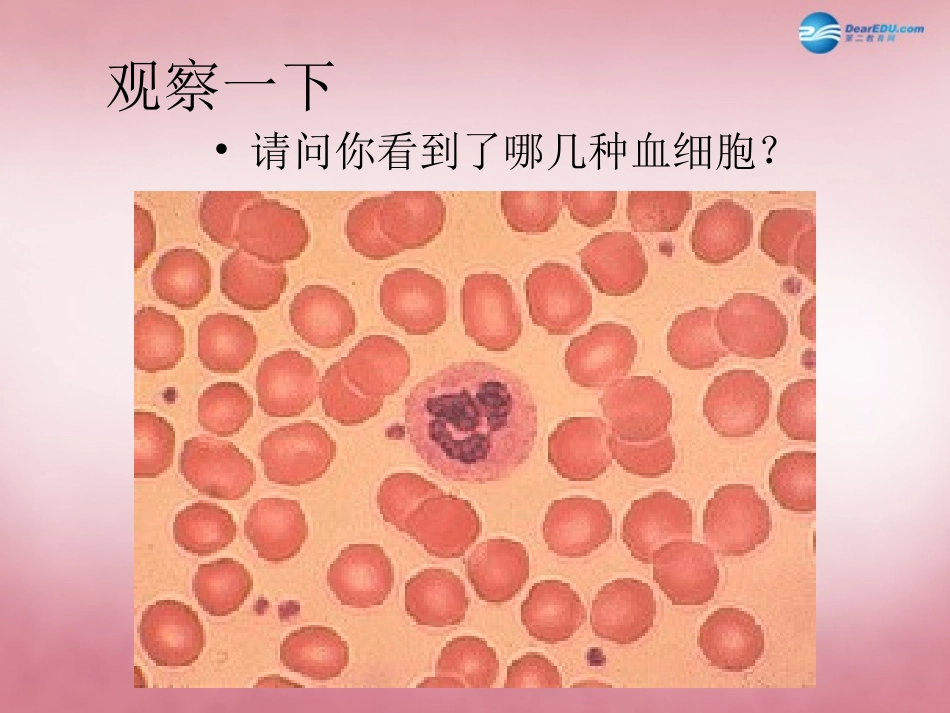
山东省肥城市王庄镇初级中学七年级生物下册 4.4.2 血流的管道—血管课件 新人教版_第3页

血──流的管道血管血液的成分与功能•啊
解释你的流血经验
•那些血有什么成分
答:血液由血细胞与血浆組成观察一下•请问你看到了哪几种血细胞
血细胞•红细胞•白细胞•血小板红细胞白细胞血小板超級比一比~血细胞外形細胞核大小功能圓球狀双凹、圓盘狀數目血小板白细胞紅细胞有最大次之無无不規則狀血液凝固防御病原体运送氧气次之最少最多最小血漿的成分与功能•血漿的主要成分是水和蛋白質•携带着养料、废物、激素血管•流血了
•答:血管是血液在体内流动的通道•血管有哪些种类
•答:血管可分为动脉、静脉与毛细血管血管的概念•何謂动脉
•何謂毛细血管
动脉、靜脉、毛细血管和心脏四者的连接情形心脏毛细血管动脉靜脉血管的形态
•超级比一比:請比较动脉、靜脉与毛细血管有何异同
超級比一比~血管动脉最薄次之最厚动脉到靜脉流回心房离开心室流动方向毛细血管靜脉次之最大管壁彈性最小最大次之口徑大小管壁厚薄无无有脉博最慢次之血流速度最快几乎沒有打針
•十年后你成为了一位南丁格尔,当你要对病人的手臂打针,請問你要將針刺入哪一种血管
你的理由为何
•如果你是氧气,你会选择从哪一种血管进入細胞內
問題討論•請画图表示氧气、养料、二氧化碳、废物在細胞与毛细血管间的交換方向养料废物氧气二氧化碳毛细血管細胞細胞与毛细血管间的交換考考你1
动脉和静脉的名称各是根据什么而定的
(血流方向)
了不起,你真行
某些病人需要输液治疗时,护士把针头插入到病人的哪些血管里
完全正确,你很聪明
静脉瓣的作用全身血管心脏毛细血管